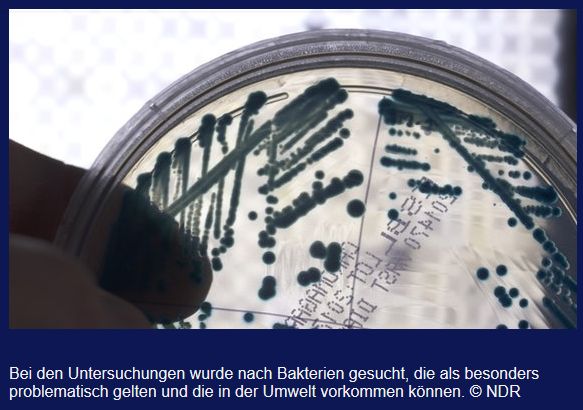

30.01.2019
Hamburg startet Test mit E-Rezept

- Foto: NeiFo /Pixabay CC0
Nach Informationen des NDR startet in Hamburg die Techniker Krankenkasse (TK) bundesweit den ersten Versuch mit dem sogenannten E-Rezept - einem Code fürs Handy. Im Stadtteil Wandsbek konnten sich von Februar an Ärzte, Apotheker und Patienten für das Projekt einschreiben. Ziel ist es, Erfahrungen zu sammeln, um im nächsten Schritt dann auch andere Hamburger Stadtteile und die Versicherten anderer Krankenkassen mit einzubeziehen.
Derzeit werden bundesweit jährlich etwa 450 Millionen Rezepte ausgestellt, auf Papier natürlich. Allein in Hamburg sind das pro Jahr etwa zehn Millionen Stück. Das soll sich künftig ändern. Grundlage hierfür ist das Gesetz für mehr Sicherheit in der Arzneimittelversorgung, das zur Zeit im Kabinett in Berlin beraten wird. In Zukunft sollen Patienten statt eines rosafarbenen Zettels, einen digitalen Code vom Arzt aufs Handy geschickt bekommen. In der Apotheker wird der Code gescannt und der Patient erhält das verordnete Medikament. Vorteil: Die Patienten müssen nicht mehr für ein Folgerezept in die Praxis und das verkürzt dort am Empfang die Warteschlangen. (Quelle: NDR)
Das Hamburg Journal war exklusiv bei den Vorbereitungen dabei und berichtet heute, 30. Jan., um 19.30 Uhr im NDR Fernsehen.
red
Lesen Sie auch:

Sarah Baker Foto: LLL/flickr CC
Hoffnung für den Klimaschutz
Wissenschaftler am Lawrence Livermore Forschungslabor haben nicht nur den Schlüssel gefunden, mit...

Foto: Pixabay CC/PublicDomain/Pexels
Kehrseite des Sportevents: Tonnenweise Essensmüll
Superbowl: In der Nacht des Football-Endspiels der besten Teams verzehren die Zuschauer – im...

Foto: Pixabay CC/PublicDomain/Arek Socha
Neuer Ansatz für Ökoenergie: Strom aus Wassertropfen
Neue, Idee für die Energiewende: Wissenschaftler der City University Hongkong entwickelten einen...
Neu im global° blog
Foto: Pressenza (CC BY 4.0)
Atomwaffen verstoßen gegen das Recht auf Leben
Die Organisationen IALANA, IPPNW und ICAN weisen anlässlich des Tages der Menschenrechte auf den...

Foto: ZDF / Martin Kaeswurm
"Schattenmacht Blackrock"
Der amerikanische Finanzinvestor Blackrock verwaltet im Auftrag seiner Kunden über sechs Billionen...

Screenshot: gunther-moll.de
Die Botschaft
Eine lebenswerte Zukunft im Einklang mit der Natur ist auf diesem Planeten möglich, wenn wir uns...